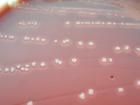
中間型鏈球菌 中間型鏈球菌

簡介
中間型鏈球菌中間型鏈球菌為一組鏈球菌(Str. intermediusgroup),包括3個菌種,即中間型鏈球菌(Str.intermedius)、星座鏈球菌(Str.contellatus)和咽峽鏈球菌(Str.anginosus)。中間型鏈球菌93%非β-溶血,38%的星座鏈球菌和12%的咽峽鏈球菌呈β-溶血。
寄生環境
該組細菌主要存在於人類口腔中,可自牙齦縫隙、牙斑、根管中分離獲得,也存在於喉和鼻咽部,尚寄殖在胃腸道。
引發病症
該組細菌可致牙齦膿腫,並可由此引致敗血症、心內膜炎。值得注意的是該組鏈球菌尚可引起腦膿腫,並常與厭氧菌同時存在。腹膜炎、肝膿腫、盆腔膿腫亦可發現。口咽部存在的中間型鏈球菌組細菌的吸入可導致吸入性肺炎,並可並發肺膿腫和膿胸,發生縱隔炎者亦有報導。其他尚可引起骨髓炎、化膿性關節炎、鼻竇炎、皮下膿腫、蜂窩織炎等。
益生菌
| 益生菌是指維持腸道微生物平衡的有機體,是存在於自然界的有益微生物。目前益生菌已被套用於飼料、農業、醫藥保健和食品等各領域。在飼料工業上多採用地衣芽孢桿菌和蠟狀芽孢桿菌,在農業上多採用蘇芸金桿菌和蠟狀芽孢桿菌,在醫藥保健多採用乳酸菌、雙岐桿菌和腸球菌,在食品上多採用酵母菌等。 |